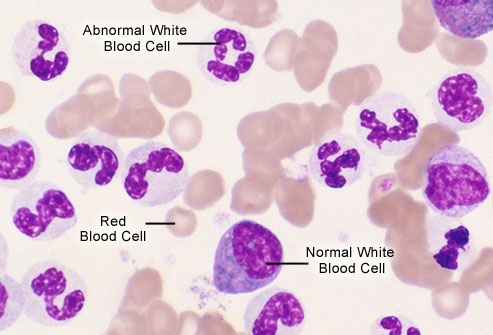

Unveiling The Distinct Battles: Chronic Myeloid Vs. Chronic Lymphocytic Leukemia. Greetings to a place where each photo tells a story. In this site, we're excited to share captivating ideas, a collection of captivating photos, and inspiration that could change your view on the world and broaden your knowledges. This journey starts with the image you see here.
If you are searching about Chronic lymphocytic leukemia flashcards, you've came to the right web. We have 35 images about Chronic lymphocytic leukemia flashcards, such as Chronic lymphocytic leukemia vs chronic myeloid leukemia, Chronic myeloid leukemia, and also Chronic leukemia vs acute leukemia. Here you go:
(pdf) Unveiling The Rarity: Chronic Myeloid Leukaemia In Children And Adults: A Comparative Analysis
Chronic lymphocytic leukemia: symptoms, stages, treatments. leukemia symptoms in adults. chronic myeloid leukemia stock illustrations. Simultaneous chronic myeloid leukemia and chronic lymphocytic leukemia. Chronic myeloid leukemia calgary guide. Chronic leukemia vs acute leukemia. Chronic lymphocytic leukemia prevalence incidence. chronic myeloid leukemia calgary guide. (pdf) n-methyladenosine (ma) rna modification in chronic myeloid leukemia: unveiling a novel

(pdf) N-methyladenosine (ma) Rna Modification In Chronic Myeloid Leukemia: Unveiling A Novel
Zanubrutinib shows superior progression-free survival vs ibrutinib in chronic lymphocytic leukemia. Acute vs chronic leukemia chart. (pdf) unveiling the rarity: chronic myeloid leukaemia in children and adults: a comparative analysis. chronic leukemia vs acute leukemia. chronic leukemia vs acute leukemia. Chronic myeloid leukemia vs. chronic lymphocytic leukemia. (pdf) unveiling the rarity: chronic myeloid leukaemia in children and adults: a comparative analysis. chronic myeloid leukemia vs. chronic lymphocytic leukemia. chronic lymphocytic leukemia: symptoms, stages, treatments

Chronic Leukemia Vs Acute Leukemia
Acute vs chronic leukemia chart. Chronic leukemia vs acute leukemia. chronic leukemia vs acute leukemia. (pdf) unveiling the rarity: chronic myeloid leukaemia in children and adults: a comparative analysis. (pdf) n-methyladenosine (ma) rna modification in chronic myeloid leukemia: unveiling a novel. chronic leukemia vs acute leukemia. Simultaneous chronic myeloid leukemia and chronic lymphocytic leukemia. Aml vs. cml: how are these leukemia types different?. Leukemia symptoms in adults

Chronic Myeloid Leukemia
chronic lymphocytic leukemia vs chronic myeloid leukemia. Chronic leukemia vs acute leukemia. Zanubrutinib shows superior progression-free survival vs ibrutinib in chronic lymphocytic leukemia. Acute lymphoblastic leukemia vs. chronic lymphocytic leukemia. chronic myeloid leukemia (cml). chronic myeloid leukemia: causes, symptoms & treatment. Four types of leukemia. acute myeloid, chronic lymphocytic type stock vector. leukemia symptoms in adults. chronic lymphocytic leukemia
Simultaneous Chronic Myeloid Leukemia And Chronic Lymphocytic Leukemia
You Might Also Like: 0895403292432 Agen Skincare Usaha
Aml vs. cml: how are these leukemia types different?. Chronic lymphocytic leukemia: slow-appearing symptoms. chronic myeloid leukemia stock illustrations. chronic leukemia vs acute leukemia. Chronic lymphocytic leukemia diagram. chronic myeloid leukemia. Simultaneous chronic myeloid leukemia and chronic lymphocytic leukemia. Acute lymphoblastic leukemia vs. chronic lymphocytic leukemia. Chronic lymphocytic leukemia: symptoms, stages, treatments
0 Comments: